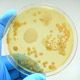

RIKEN Center for Biosystems Dynamics Research (BDR)
 Director: Ryoichiro Kageyama (M.D., Ph.D.)
Director: Ryoichiro Kageyama (M.D., Ph.D.)
BDR views the life cycle of organisms, from development and birth to aging, as a continuous sequence of multilayered biological processes. We promote research to understand the biological processes across hierarchical levels and spatiotemporal scales and develop technologies for predicting and controlling life cycle progression. Through the synergy of these studies, we strive to uncover new scientific findings for organisms to maintain healthy states across their life cycle and contribute to finding solutions to issues faced by aging societies with declining birthrates.
BDR employs an integrative approach to achieve this aim, leveraging technologies and methods related to stem cells, germ cells, organoids, diverse animal models, multiscale imaging and quantification techniques, mathematical modeling, AI and foundation models, robotics, and multiscale simulations.
Deputy Director: Makoto Taiji (D.Sc.), Tomoya Kitajima (Ph.D.), Yasushi Okada (M.D., Ph.D.), Mitsuru Morimoto (Ph.D.)
Organization
- Laboratory for AI Biology
- Haruka Ozaki (Ph.D.)
- Laboratory for Nutritional Biology
- Fumiaki Obata (Ph.D.)
- Laboratory for Computational Molecular Design
- Makoto Taiji (D.Sc.)
- Laboratory for Vascular Morphogenesis
- Li-Kun Phng (Ph.D.)
- Laboratory for Lung Development and Regeneration
- Mitsuru Morimoto (Ph.D.)
- Laboratory for Tissue Microenvironment
- Hironobu Fujiwara (Ph.D.)
- Laboratory for Cell Polarity Regulation
- Yasushi Okada (M.D., Ph.D.)
- Laboratory for Prediction of Cell Systems Dynamics
- Katsuyuki Shiroguchi (Ph.D.)
- Laboratory for Epithelial Morphogenesis
- Yu-Chiun Wang (Ph.D.)
- Laboratory for Neural Stem Cell Research
- Ryoichiro Kageyama (M.D., Ph.D.)
- Laboratory for Heart Regeneration
- Wataru Kimura (Ph.D.)
- Laboratory for Genetic Engineering Technology
- Hiroshi Kiyonari (Ph.D.)
- Laboratory for Human Biomimetic System
- Masaya Hagiwara (Ph.D.)
- Laboratory for Chromosome Segregation
- Tomoya Kitajima (Ph.D.)
- Laboratory for Comprehensive Bioimaging
- Tomonobu Watanabe (Ph.D.)
- Laboratory for Multiscale Biosystem Dynamics
- Chikara Furusawa (Ph.D.)
- Laboratory for Ultrastructural Research
- Satoko Arakawa (Ph.D.)
- Laboratory for Quantitative Biology of Cell Fate Decision
- Yumi Konagaya (Ph.D.)
- Laboratory for Hibernation Biology
- Genshiro A. Sunagawa (M.D., Ph.D.)
- Laboratory for Homeodynamics
- Sa Kan Yoo (M.D., Ph.D.)
- Laboratory for Brain Organoid
- Hideyuki Okano (M.D., Ph.D.)
- Laboratory for Brain Connectomics Imaging
- Takuya Hayashi (M.D., Ph.D.)
- Laboratory for Biologically Inspired Computing
- Koichi Takahashi (Ph.D.)
- Laboratory for Gametogenesis
- Hiroki Shibuya (Ph.D.)
- Laboratory for Developmental Epigenetics
- Ichiro Hiratani (Ph.D.)
- Laboratory for Developmental Morphogeometry
- Yoshihiro Morishita (Ph.D.)
- Laboratory for Developmental Genome System
- Takefumi Kondo (Ph.D.)
- Laboratory for Developmental Dynamics
- Shuichi Onami (D.V.M., Ph.D.)
- Laboratory for Comparative Connectomics
- Kazunari Miyamichi (Ph.D.)
- Laboratory for Human Organogenesis
- Minoru Takasato (Ph.D.)
- Laboratory for Physical Biology
- Tatsuo Shibata (Ph.D.)
- Laboratory for Multimodal AI Framework
- Ryosuke Kojima (Ph.D.)
- Laboratory for Cell-Free Protein Synthesis
- Yoshihiro Shimizu (Ph.D.)
- Chrono-Developmental Biology RIKEN ECL Research Team
- Masayuki Oginuma (Ph.D.)
- Metabolic and Behavioral Physiology RIKEN ECL Research Team
- Chisako Sakuma (Ph.D.)
- Technology Platform Division
- Yasushi Okada (M.D., Ph.D.)
-
- Genomics Research and Analysis Support Team
- Takefumi Kondo (Ph.D.)
- Optical Microscopy and Engineering Support Team
- Tomonobu Watanabe (Ph.D.)
- Super-Resolution Bioimaging Support Team
- Yasushi Okada (M.D., Ph.D.)
- Data Management Team
- Shuichi Onami (D.V.M., Ph.D.)
- Electron Microscopy Imaging Support Team
- Satoko Arakawa (Ph.D.)
- Animal Resources Core Team
- Hiroshi Kiyonari (Ph.D.)
- Mass Spectrometry Analysis Team
- Yoshihiro Shimizu (Ph.D.)
- Laboratory Robotics Operations Team
- Koichi Takahashi (Ph.D.)
- Drug Discovery Molecular Simulation Platform Unit
- Makoto Taiji (D.Sc.)
- RIKEN BDR-Otsuka Pharmaceutical Collaboration Center
- Ryoichiro Kageyama (M.D., Ph.D.)
- Structural Life Science and Cell Biology Collaboration Team
- Ryoichiro Kageyama (M.D., Ph.D.)
- Advanced General Intelligence for Science Collaboration Team
- Ryoichiro Kageyama (M.D., Ph.D.)
Recent Research Results

Mar. 11, 2026
Taking the pressure off aging chromosomes during meiosis






Sep. 11, 2025
How egg cells control the timing of cell division
Publications
Related Links
Careers
| Position | Deadline |
|---|---|
| Seeking a Senior Research Scientist, Research Scientist or Postdoctoral Researcher (25-3469) | Jun. 30, 2026 |
Job Openings
Contact Information
2-2-3 Minatojima-minamimachi, Chuo-ku
Kobe, Hyogo
650-0047 Japan
Contact | RIKEN Center for Biosystems Dynamics Research
